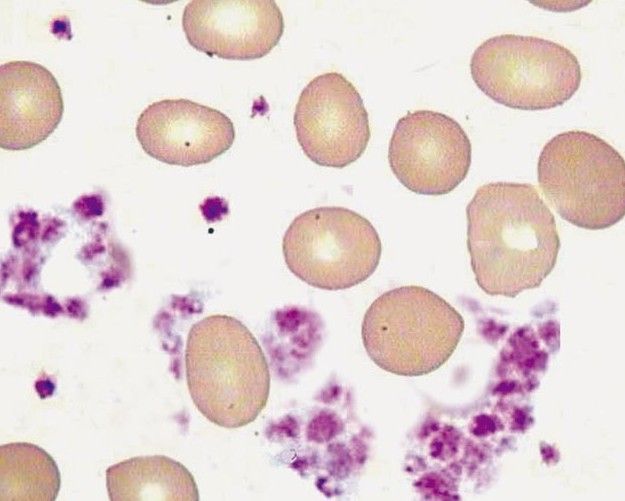

据了解,BioMarin Pharmaceutical宣布Palynziq(pegvaliase-pqpz)注射剂获得美国FDA的标准批准(standard approval),用于降低苯丙酮尿症(PKU)成人患者的血液苯丙氨酸(Phe)水平。在现有管理下,这些患者要将其血液Phe浓度控制在600微摩尔/升以内是极难做到的。值得关注的是,这是首个获批能通过帮助身体分解Phe来靶向PKU潜在病因的酶替代疗法;同时,也是BioMarin针对这一重要病症的第二款批准疗法。
苯丙酮尿症(PKU)是一种常见的氨基酸代谢病,是由于苯丙氨酸(PA)代谢途径中的酶缺陷,使得苯丙氨酸不能转变成为酪氨酸,导致苯丙氨酸及其酮酸蓄积,并从尿中大量排出。本病在遗传性氨基酸代谢缺陷疾病中比较常见,其遗传方式为常染色体隐性遗传。临床表现不均一,主要临床特征为智力低下、精神神经症状、湿疹、皮肤抓痕征及色素脱失和鼠气味等、脑电图异常。如果能得到早期诊断和早期治疗,则前述临床表现可不发生,智力正常,脑电图异常也可得到恢复。
Palynziq是一种聚乙二醇化的重组苯丙氨酸解氨酶,用来替代PKU患者缺乏的苯丙氨酸羟化酶(PAH)以分解Phe。它的效果在临床试验中得到证实。在关键3期研究PRISM-2中,Palynziq与安慰剂相比显著降低了血液Phe水平(p<0.0001),抵达了血液Phe变化的主要终点。在PRISM-2双盲、安慰剂对照、随机停药期试验(RWP)中,患者以2:1的比例被随机分配继续接受Palynziq治疗(每日20 mg或每日40 mg)或接受安慰剂,持续8周。结果显示,Palynziq组患者可以维持血液Phe浓度,而安慰剂组患者的血液Phe浓度恢复到治疗前基线。
“BioMarin很高兴能够为无法通过现有选择控制Phe水平的PKU成人患者提供这种重要的新疗法。Palynziq的批准是BioMarin员工十多年坚持不懈的结果,”BioMarin董事长兼首席执行官Jean-Jacques Bienaimé先生说:“我们为取得这项成就而自豪,感谢FDA,感谢PKU患者的积极参与。”
“治疗PKU的目标是将血液Phe水平保持在医学指南中设定的范围内,因为Phe升高可能对大脑产生毒性并造成损害。Palynziq为我们提供了另一个非常需要的工具,帮助成人患者控制其Phe水平,这对于许多患者来说曾经是无法实现的。”俄勒冈健康与科学大学(Oregon Health & Science University )教授、3期研究研究员Cary Harding博士说。
Palynziq预计在6月底会在美国上市。期待这款新药能为PKU患者切实带来福音,能为他们提供多一种有效的治疗选择。
News
相关文章
2023-09-07
2021-10-07
2021-10-08
2021-10-14
2021-10-15
2021-10-19
2021-10-20
2021-10-22
2021-10-22
2021-10-22
Next
下一篇